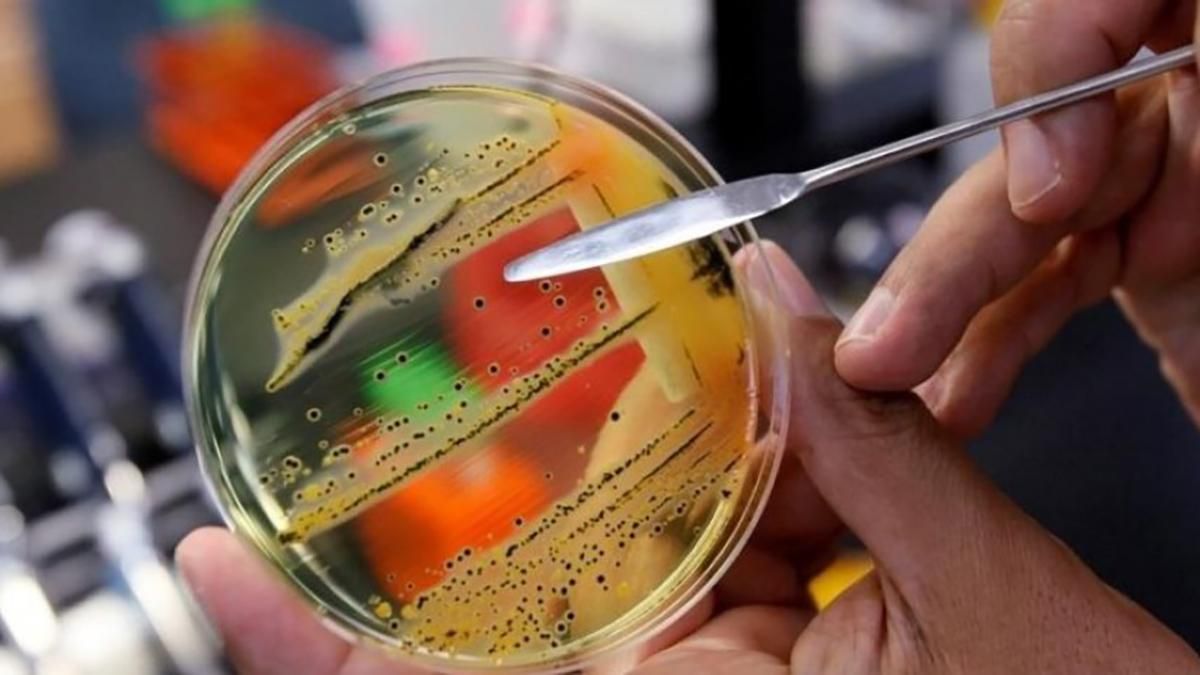
Отравление в Харькове в Якитории 22 июня 2021: какая причина Отравление в Харькове в Якитории 22 июня 2021: какая причина

Кроме этого, возросло количество пациентов. О результатах анализов сообщили 22 июня, через 5 дней после инцидента.
К теме Массовое отравление суши в Харькове: пострадавших начали выписывать
Подробнее о заболеваниях пострадавших
По словам специалиста, уже появились результаты первых анализов. Их пробы собрали сразу после инцидента, 17 июня.
Сейчас в анализах 42 больных обнаружили сальмонеллу. Исследование этой культуры сейчас продолжается, то есть идет ее идентификация, изучается ее биохимические свойства. Это позволит впоследствии определить конечный диагноз.
Что показало обследование персонала
Также сдали анализы работники заведений питания. У нескольких из них обнаружили Staphylococcus Aureus в образцах анализов из носа. Поскольку это свидетельствует о том, что эти люди являются возбудителями инфекции, поэтому им нельзя работать.
Еще 1 больной сальмонеллой есть среди работников. Этот человек уже госпитализирован.
В заведениях была антисанитария
Суспільне пишет, что о причинах отравления рассказала заведующая отделом эпидемиологического надзора областного центра контроля и профилактики болезней Татьяна Карлова. По ее словам, на поверхностях в ресторанах обнаружили флору Klebsiella Pneumoniae. Это условно патогенный организм, который во время накопления также может вызывать инфицирование.
А вот представителей бактерий Salmonella Enteritidis обнаружили на доске для нарезания. Кроме этого сальмонеллу нашли в роллах, которые заказывали в заведении. Это были роллы, которые в своем составе имели омлет, мягкий сыр, рыбу, огурец и паштет.
Это все происходит из-за несоблюдения санитарно-гигиенических условий, то есть практически можно сказать, антисанитария происходила в этом заведении,
– пояснила Татьяна Карлова.
Больные продолжают обращаться
- Количество пострадавших в этом отравлении растет.
- Всего их уже 87.
- Из этих людей – 19 детей.
- На амбулаторном лечении находятся только 4 пациентов.
- Остальные госпитализированы в различные медучреждения.
- Их состояние определяют, как удовлетворительное.
Кратко об отравлении в "Якитории"
- Все пострадавшие ели в одном из 2 харьковских заведений японской кухни.
- После этого количество больных неуклонно растет.
- В заведениях взяли пробы и отправили их на анализ.
- В сети сказали, что окажут материальную помощь пострадавшим.
- По состоянию на 19 июня пострадавших было уже почти 80.
- По состоянию на 22 июня, "Якитория" перевела на лечение 150 тысяч гривен.
- Впоследствии начали расследование этого инцидента и в полиции.
- Там его считают нарушением санитарных правил по предотвращению массовых отравлений.
- Виновным грозит до 3 лет заключения.
- Часть пострадавших начали выписывать 22 июня.